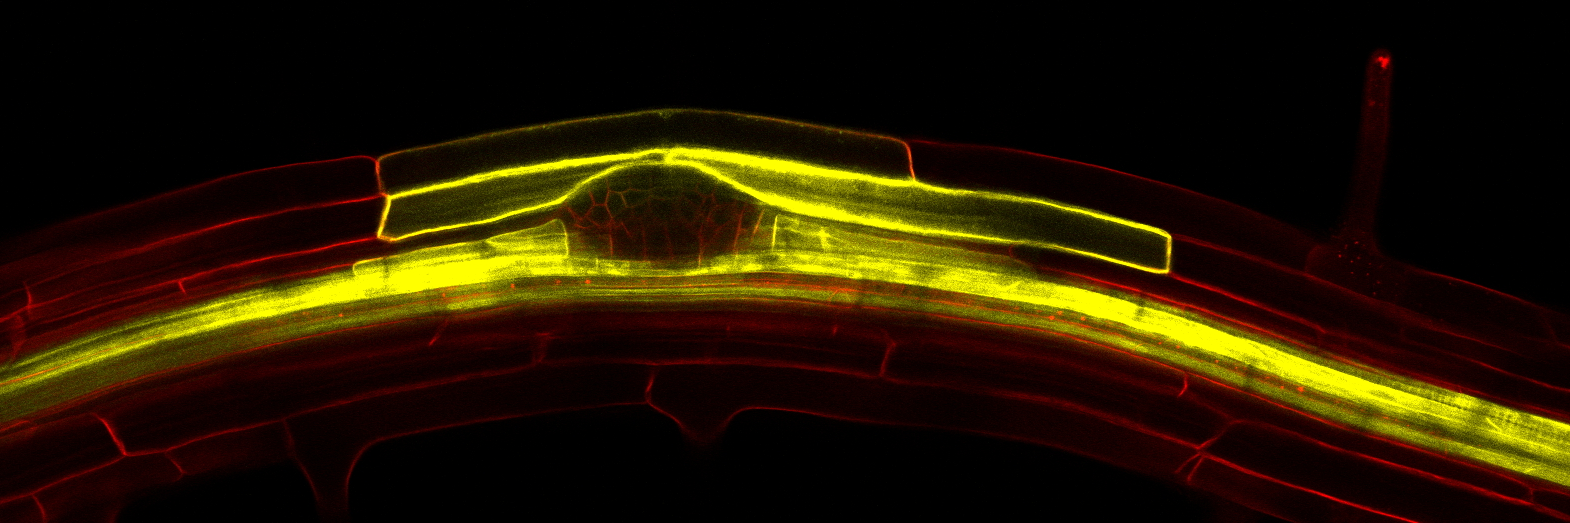
Peret lab banner

Peret lab
1.2K posts

Peret lab
@PeretLab
Plant scientist interested in root development, hormonal responses and adaptation to the environment.












Honored to receive the PCP Best Paper Award for our research on cellular dynamics at the growing root tip! 🏆 This research was made possible by an amazing interdisciplinary collaboration. Huge thanks to my co-authors and everyone who supported us! 🙌


Online now: MCTP controls nucleocytoplasmic partitioning of AUXIN RESPONSE FACTORs during lateral root development dlvr.it/TFS7Kv



A novel toolbox of GATEWAY-compatible vectors for rapid functional gene analysis in soybean composite plants biorxiv.org/cgi/content/sh… #biorxiv_plants



Autoregulation of cluster root and nodule development by white lupin CCR1 receptor-like kinase biorxiv.org/cgi/content/sh… #biorxiv_plants




